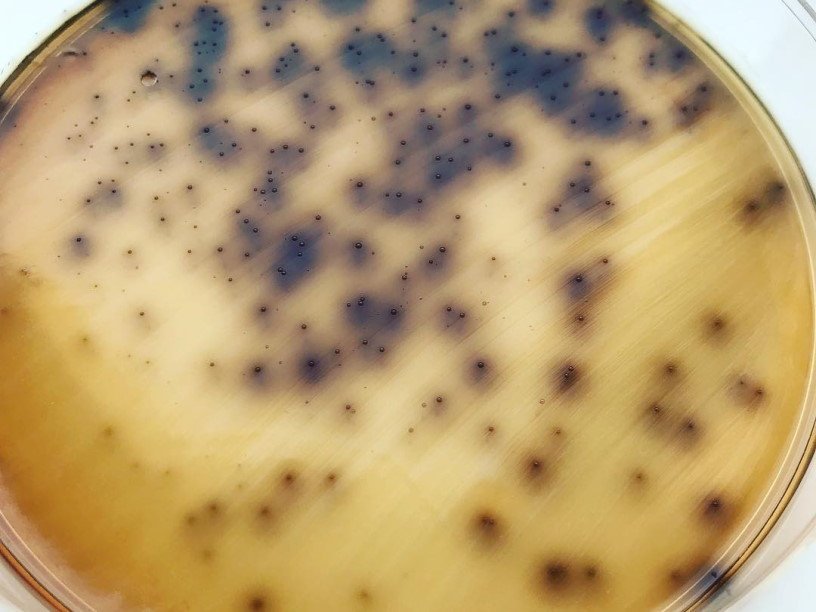

Екатерина Беленко: Промикробы: Гонка вооружений
Фото: Екатерина Беленко
Фото: Екатерина Беленко Недавно наткнулась на мем с двумя собачками — маленькой жалкой и большой грозной. Ну, вы наверняка видели такие. Только этот был про бактерии. Бактерий раньше олицетворяла маленькая собачка, и подпись гласила «О нет, пенициллин((», а большая собака — это современные супербактерии, имеющие резистентность ко всем или почти всем антибиотикам. И смешно, и немного страшно одновременно.
⠀
Конечно, далеко не все микробики стали такими опасными и неубиваемыми. Одним из представителей «неудержимых» бактерий является энтерококк. Я уже про него рассказывала, правда, очень давно. Чтобы освежить знакомство, ищите статью под названием «Тёмная сторона силы». Энтерококки являются основными симбиотическими организмами кишечника человека, особенно распространены и значимы два вида — Enterococcus faecalis и Enterococcus faecium. И хоть они наши близкие соседи, но могут вызывать множество самых разных патологических процессов. Раньше проблем с лечением не возникало, были антибиотики, которые всегда без промахов убивали энтерококков, например, ванкомицин и линезолид. Но в последние несколько десятилетий устойчивость к некоторым противомикробным препаратам резко возросла, особенно среди E. faecium.
⠀
Ванкомицин — антибиотик из группы трициклических гликопептидов. Является одним из наименее преодолимым для суперрезистентных бактерий, так называемым антибиотиком стратегического запаса и лекарством последней надежды. Но даже здесь не обошлось без «но». Механизм бактерицидного действия обусловлен ингибированием биосинтеза клеточной стенки. Кроме того, ванкомицин может изменять проницаемость клеточной мембраны бактерий и изменять синтез РНК. Ушлые энтерококки научились менять пути синтеза пептидогликана (основной строительный материал клеточной стенки), делая его неуязвимым для ванкомицина.
⠀
Ванкомицин активен в отношении грамположительных микроорганизмов, включая Staphylococcus aureus, Staphylococcus epidermidis, Streptococcus pyogenes, Streptococcus pneumoniae, Enterococcus spp., Clostridium difficile, Corynebacterium diphtheriae. Но, как вы уже поняли, некоторые штаммы энтерококков и стафилококков проявляют устойчивость к ванкомицину. Кроме того, ванкомицин совершенно бесполезен в отношении грамотрицательных микроорганизмов, микобактерий и грибов.
⠀
Для обозначения энтерококков, которые не боятся ванкомицина, даже есть отдельная аббревиатура — ВРЭ, то есть ванкомицин-резистентный энтерококк. Сами понимаете, для чего-то редкого и неважного не будут придумывать отдельную аббревиатуру. Заразиться инфекцией, вызываемой ВРЭ, с большей вероятностью могут люди с ослабленной иммунной системой, страдающие хроническими заболеваниями, раком или диабетом. Кроме того, люди, активно принимавшие антибиотики, недавно перенесшие операцию, лежавшие в больнице много раз или длительное время, а также люди с установленными трубками и дренажами. Как ни ухаживай за подобными устройствами, как ни блюди их стерильность, но инородный предмет есть инородный предмет. Поэтому желаю всем нам обходиться без таких штуковин и не встречаться с суперинфекциями.
Смотрите также: Екатерина Беленко Промикробы: Антикиллер Екатерина Беленко Промикробы: Повышенная влажность Екатерина Беленко Промикробы: Темная сторона силы Екатерина Беленко Промикробы: Загадочный дисбактериоз